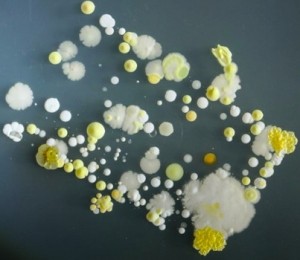

Cei mai multi medici si cele mai multe laboratoare nici macar nu includ magneziul in testele de sange de rutina. Prin urmare, cei mai multi medici nu stiu cand pacientii lor au o deficienta de magneziu, chiar daca studiile arata ca majoritatea populatiei are o problema in aceasta privinta.
Simptome ale deficientei de magneziu
Primele simptome care arata o deficienta pot fi subtile - si cum cea mai mare parte din magneziu este stocata in tesuturi, primele semne pot fi crampele la nivelul picioarelor, durerile la nivelul picioarelor sau atunci cand simti ca muschiul se "zbate".
Alte semne timpurii ale unei deficiente de magneziu sunt pierderea poftei de mancare, greata, varsaturi, oboseala, slabiciune. Pe masura ce deficienta de magneziu se agraveaza, pot aparea senzatii de amorteala, furnicaturi, convulsii, schimbari de personalitate, ritm cardiac anormal si spasme coronariene.
O scurta lista care arata simptomele timpurii ce sugereaza o insuficienta de magneziu:
* oboseala fizica si psihica
* acea senzatie permanenta cand ti se zbate ochiul sau pleoapa
* tensiune in partea superioara a spatelui, umerilor si gatului
* dureri de cap
* retentie de apa inainte de menstruatie si/sau sensibilitarea sanilor.
Posibile manifestari ale deficientei de magneziu includ:
* un nivel scazut de energie
* oboseala
* slabiciune
* confuzie
* nervozitate
* anxietate
* irascibilitate
* convulsii
* digestie proasta
* sindromul premenstrual si dezechilibre hormonale
* imposibilitatea de a dormi
* tensiune musculara, spasme si crampe
* calcifierea organelor
* slabiciune la nivelul oaselor
* ritm cardiac anormal.
Semne care arata o deficienta severa de magneziu:
* sete extrema
* foame extrema
* urinat frecvent
* rani sau vanatai care se vindeca incet
* piele uscata, cu senzatie de mancarime
* pierdere inexplicabila in greutate
* vedere incetosata care se schimba de la o zi la alta
* oboseala neobisnuita sau somnolenta
* furnicaturi sau amorteala la nivelul mainilor sau picioarelor
* infectii frecvente sau recurente la nivelul pielii, gingiilor, vezicii sau vaginului. Sursa.
Citeste si: 5 semne care indica o deficienta de vitamina D
13 semne care arata ca ai o deficienta de vitamina B12









































 5 mirodenii care te ajuta sa slabesti
5 mirodenii care te ajuta sa slabesti
FOTO dezgustator: Telefonul tau este acoperit in intregime de...
FOTO dezgustator: Telefonul tau este acoperit in intregime de...


































